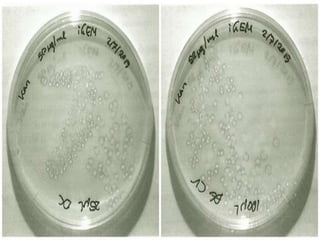

This document discusses Good Laboratory Practices (GLP) regulations and microbiology laboratory practices. It provides background on how GLP regulations were developed in response to malpractice issues and aim to ensure proper management and organization of studies. The key points of GLP include resources, characterization of test items, study plans and procedures, documentation of results, and quality assurance. The document also outlines biosafety levels and practices for handling different types of microorganisms, as well as guidelines for media preparation, culture maintenance, laboratory equipment use, and safety.